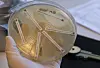

Medicin
Forskare i Israel: Människokroppen har potential att generera antibiotika
Israeliska forskare tror sig ha upptäckt ett naturligt kroppsligt försvar mot bakteriella infektioner. Genrebilden är från ett smittskyddslaboratorium i Stockholm.
Fredrik Sandberg/TT
Antibiotikaresistens bedöms årligen kosta över en miljon människor livet. Nu tror israeliska forskare att människokroppen har potential att generera naturlig ”antibiotika”.
– Det här är verkligen spännande, säger professorn Yifat Merbl till BBC.
Forskare
i Israel säger sig ha upptäckt att den del av kroppen som återvinner proteiner
har kapacitet att ”spy ut en arsenal av
bakteriedödande kemikalier”. Denna upptäckt förändrar, enligt forskarna, förståelsen
för människors naturliga skydd mot infektioner.
ERBJUDANDE!
Världen idag DIGITAL
2 månader för 10 kr!
KÖP
Världen idag
DIGITAL
139,-
kr/månad
KÖP
Världen idag
PAPPER
229,-
kr/månad
KÖP